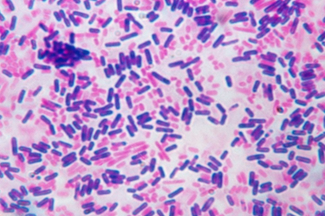

Gram staining

Content:
• About
• Principle
• Materials required
• Procedure
• Observation
• Results
• Limitations.
About:
- Gram staining is one of the most useful techniques used for the identification of bacterial population.
- Developed by Hans Christian Gram a Danish Bacteriologist in 1884.
- The procedure includes staining of bacteria and observation under microscope.
- The organisms are differentiate on the basis of holding of stain, the organism called to be gram positive if it retain crystal violet after decolourization and appear purple while the gram negative bacteria after decolourisation appear pink to red in colour because of the safranin counter stain.
Principle:
The differences in gram positive and gram negative is due the difference in the cell wall composition of the bacteria.
- Cell wall of a gram positive bacterium consist of a thick layer of peptidoglycan layer with numerous teichoic acid this complex structure resist decolourization.
- Cristal violet (primary stain) penetrates cell wall and cell membrane after that iodine is used as moderant, crystal violet interacts with iodine and peptidoglycan layer and makes a complex called cv-I complex. Even after decolourizer is applied CV-I complex retains in the cell and making it to appear purple to dark blue.
- In gram negative bacteria there is a thin peptidoglycan layer with loose cross linkage. The peptidoglycan layer is distributed loosely in inner and outer cell membrane. After the application of cristal violet and iodine on the cells, CV-I complex is not trapped in the peptidoglycan layer and decolourizer makes hole in the layer which allow to wash out the CV-I complex from cell and leaves the cell colourless. To make colourless cell visible a counter stain is used called safranin which gives pink to red colour.
Material required and Reagents:
- Glass slide
- Bunsen burner
- Microbial strain (fresh 24 hours incubated)
- Crystal violet
- Gram’s Iodine
- Safranin
- 70% ethyl alcohol
- Dropper
- Microscope
Procedure to follow:

- Clean a microscope slide and make a smear of distilled water.
- With the help of an inoculation loop pic a minute portion from the isolated colony and mix it with the smear on slide to make a thin smear.
- Air-dry the slide at room temperature.
- Ignite a Bunsen burner and heat fix the smear by heating the slide over the flame (not overheat).
- Pour some drops of crystal violet over the smear and wait for 1 min
- Slowly pour cold-water on the slide from the edges to wash out excess crystal violet .
- Flood the slide with iodine wait for 1 minute and then wash if off.
- Decolourize with the help of ethyl alcohol until colourless slide is appear.
- Now add few drops of counter stain i.e. safranin to the smear and left for 30 second, then wash it off.
- Dry the slide with bloating paper
- Observe the slide under microscope at 40X or 100X.
Observation:
- Examine properly the slide an identify the gram reaction, describes morphology and arrangement of the microbial cell
Results:
- Bacteria which appeared blue colour under microscope are referred as gram negative and those cells which show pink colour are called gram negative .
Limitations:
- Over decolourization may lead to identification of false gram negative cells and under decolourization lead to identification of false gram positive cells.
- If the smear is too thick or viscous it may retain too much primary stain and makes identification difficult.
Examples:
| Type | Example |
| Gram-Positive | Staphylococcus, Clostridium, Listeria, Bacillus |
| Gram-Negative | Pseudomonas aeruginosa, Shigella spp, Yersinia pestis, E. coli |
